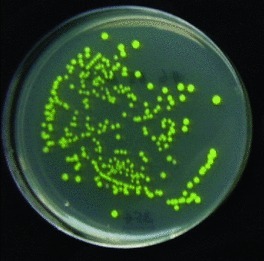
产品细节图片1

相关产品推荐更多 >
万千商家帮你免费找货
0 人在求购买到急需产品
- 详细信息
- 询价记录
- 文献和实验
- 技术资料
- 服务名称:
大肠杆菌蛋白表达
- 提供商:
武汉金开瑞生物工程有限公司
- 规格:
视具体情况而定,详情请咨询
金开瑞的大肠杆菌表达平台可提供全方位的重组蛋白生产服务,在表达包括可溶性蛋白、包涵体、融合蛋白等方面,拥有丰富的经验和专业技术,能解决蛋白表达过程中的各种瓶颈问题。到目前为止,已为全球各地客户提供超过3000种蛋白。
服务优势
1、His、GST、MBP等标签多种表达方式同时进行,确保获得zui优质的蛋白;
2、保证蛋白为普通缓冲可溶;
3、纯化的蛋白经过ELISA,Western-blot,或者其它生物活性验证;
4、可提供详细的表达纯化条件,实验数据以及菌株。
客户提供
目的蛋白信息或基因序列,质粒(也可以选择由金开瑞提供);
蛋白询价信息表(请点击下载中心,下载蛋白询价信息表后详细填写)。
最终交付
蛋白纯品,纯度90%以上;
蛋白表达结题报告,包括测序报告、实验条件、蛋白表达纯化检测结果。
服务内容
|
服务名称
|
服务项目
|
服务内容
|
交付结果
|
服务周期
|
|
普通型大肠杆菌重组蛋白表达服务
|
质粒构建
|
采用GST、Trx、SUMO、BMP、His、HA、Flag、myc等多种标签载体进行重组载体构建,可采用PTG、阿拉伯糖、热休克、冷休克等多种诱导方式。
|
表达质粒 测序报告
|
1周
|
|
表达菌株筛选
|
转化表达质粒于高效表达E.coli菌株,SDS-PAGE电泳检测挑选合适的单克隆菌株用于目的蛋白表达。BL21 (DE3)、BL21 (DE3) pLys、 Golden、Rosetta(DE3)、 RosettaBlue(DE3)、Rosetta gami B (DE3)、C41、Arctic express等多种宿主菌株供选择。
|
表达菌株 SDS-PAGE图谱
|
3个工作日
|
|
|
目标蛋白表达及纯化、标签切除
|
摇瓶培养2-8 L重组阳性克隆诱导目的蛋白表达。通过亲和层析、离子交换、疏水及凝胶过滤等多种技术纯化目的蛋白,也可根据需求切除标签,再纯化获得目的蛋白。
|
大于1mg目的蛋白,纯度最少90%以上
|
2-3周
|
|
|
包涵体复性
|
数百种缓冲液及复性条件快速筛选得到最佳复性缓冲液及复性条件。可采用稀释复性、透析复性、柱层析复性等多种技术获得纯度大于90%的包涵体蛋白。
|
大于1mg目的蛋白
|
2-3周
|
|
|
上清保证型大肠杆菌重组蛋白表达服务
|
质粒构建
|
采用pCold-SUMO载体,SUMO标签促溶的同时采用低温诱导方式,促进蛋白的可溶性表达。
|
表达质粒 测序报告
|
1周
|
|
表达菌株筛选
|
转化表达质粒于Arctic express表达菌株,宿主在表达分子伴侣Cpn60和共分子伴侣Cpn10的同时低温诱导提高上清蛋白的表达量,SDS-PAGE电泳检测挑选合适的单克隆菌株用于目的蛋白表达。
|
表达菌株 SDS-PAGE图谱
|
3个工作日
|
|
|
目标蛋白表达及纯化、标签切除
|
摇瓶培养2-8 L重组阳性克隆诱导目的蛋白表达。通过亲和层析、离子交换、疏水及凝胶过滤等多种技术纯化目的蛋白,也可根据需求切除标签,再纯化获得目的蛋白。
|
大于1mg目的蛋白,纯度最少90%以上
|
3-4周
|
案例展示
1、GFP原核表达优化:
GFP蛋白原核表达通常以包涵体形式表达,普通光源下,极难观察到绿色荧光。我公司通过对GFP序列进行突变,并对启动子进行筛选,优化培养条件,控制表达速率,用大肠杆菌表达的GFP蛋白,完全以可溶形式表达,自然光下可见强烈的绿色荧光。
采用96孔板阵列组合pH、盐浓度、氧化还原对、分子伴侣、表面活性剂等因素。将变性蛋白加入微孔板进行快速稀释复性,快速初筛几百种复性条件。


客户经过尝试在大肠杆菌DE3中表达目的蛋白A,未能获得上清蛋白,金开瑞采用Arctic Express表达体系,采用低温诱导和分子伴侣共表达方式,历经40个工作日,获得了在上清中表达的目的蛋白,得到客户的认可。


金开瑞-提供核酸和蛋白的整体研究方案:
武汉金开瑞生物工程有限公司是一家专业致力于为全球制药企业、诊断试剂企业、科研试剂研发企业、高校和科研院所以及大型医院提供蛋白及相关研究技术服务的高新技术企业。金开瑞极其注重平台技术提升,现已有多项自主知识产权和软件著作权专利,并已通过ISO9001质量管理体系认证,2018获批“千企万人”支持计划。公司以“细胞外囊泡”研究中心、基础生物医学实验中心、蛋白抗体中心和分子生物学中心为依托,提供核酸和蛋白的整体研究方案,与众多科研单位携手开展了大量的探索项目。截止到目前,已支持客户发表科研论文达1000+篇,累计影响因子6000+。
基因服务平台——引物合成、基因合成、DNA提取、载体构建、定点突变;
分子互作研究平台——双萤光素酶报告系统、RNA pull down、RIP/RIP-seq、EMSA等;
蛋白表达平台——提供从基因合成到蛋白表达的一站式服务;
抗体定制平台——单/多克隆抗体、人源化抗体、基因工程抗体、双特异性抗体、修饰抗体、诊断抗体、小分子抗体、抗体对、噬菌体服务。
更多服务内容及优惠活动,详见公司主页:http://www.genecreate.cn/
风险提示:丁香通仅作为第三方平台,为商家信息发布提供平台空间。用户咨询产品时请注意保护个人信息及财产安全,合理判断,谨慎选购商品,商家和用户对交易行为负责。对于医疗器械类产品,请先查证核实企业经营资质和医疗器械产品注册证情况。
- 作者
- 内容
- 询问日期
 文献和实验
文献和实验相关专题 蛋白表达技术全攻略 大肠杆菌 表达蛋白以可溶和不溶两种形式存在,需要不同的纯化策略。现在,许多蛋白质正在被发现而事先并不知道它们的功能,这些自然需要将蛋白质分离出来后,进行进一步的研究来获得。 分析蛋白质的方法学现已极大的简化和改进。必须承认,蛋白质纯化比起DNA 克隆 和操作来是更具有艺术性的,尽管DNA 序列具有异乎寻常的多样性(因而它是唯一适合遗传物质的),但它却有标准的物理化学性质,而每一
%。 一、可溶性产物的纯化 (一)试剂准备 采用T7· Tag Affinity Purification Kit(T7·Tag 抗体琼脂) 大肠杆菌蛋白表达纯化的策略 (二)操作步骤 1. 100 ml 含重组表达质粒的菌体诱导后,离心5000 g×5 min,弃上清,收获菌体,用10 ml 预冷的B/W 缓冲液重悬。
蛋白表达系统已经发展到了令人惊讶的顶峰时代。最近30年来,科学家们已经推动了基因工程、重组技术、纯化指南和性质鉴定等技术的急剧发展。其中包括驾驭病毒和细菌质粒的天然性质的能力,这些“carriers”将运载外源基因到宿主细胞中,然后被转化成蛋白。经过许多年的发展,蛋白生产能力的提高已经在进一步理解基因的功能和所编码蛋白的功用和相互作用等方面起到了积极作用,也将为寻找如单克隆抗体等治疗性蛋白打下基础。Paul Berg在他1980年的诺贝尔演讲中说:“毫无疑问,重组DNA技术的应用和发展
 技术资料
技术资料资料下载:
整体服务单页 210x285mm 20230706.pdf 附 (下载 1 次)
蛋白表达抗体定制平台单页 210x285mm 2023033004.pdf 附 (下载 0 次)
请 [登录] 后再下载!










